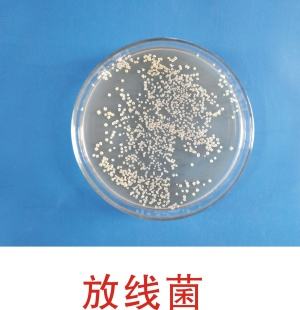

- 當(dāng)前位置:主頁 > 技術(shù)知識(shí) > 產(chǎn)品說明 >
- 固體發(fā)酵微生物菌劑原料知名生產(chǎn)企業(yè)
KNOWLEDGE
技術(shù)知識(shí)
放線菌固體發(fā)酵研究進(jìn)展
莫坤聯(lián)等采用單因子4因子3水平正交試驗(yàn)法優(yōu)化白刺鏈霉菌BWL15-4菌株及不吸水鏈霉菌BWL58菌株的固態(tài)法發(fā)酵培養(yǎng)基配方,通過單因子試驗(yàn)探討了初始pH、接種量以及培養(yǎng)溫度對(duì)2 株茵生長(zhǎng)情況的影響,并以孢子存活量多少確定了混合菌株的最適載體。BWL58優(yōu)化后的固態(tài)發(fā)酵條件為:pH7.0左右,接種量2%,發(fā)酵溫度28℃。培養(yǎng)基配方為:無機(jī)鹽水占大米重量150%,黃豆粉占大米重量的5%,麩皮占大米重量的20%,沙土占大米重量的30%。BWL15-4優(yōu)化后的固體發(fā)酵條件為 :初始pH6.3左右,接種量 3%,發(fā)酵溫度29.5℃。培養(yǎng)基配方為無機(jī)鹽水占大米重量的130%,黃豆粉占大米重量的10%,麩皮占大米重量的20%,沙土占大米重量的20%。 按照此優(yōu)化條件進(jìn)行固態(tài)發(fā)酵,白刺鏈霉 菌BWL58菌株及不吸水鏈霉菌BWL15-4菌株孢子含量可分別達(dá)到1013cfu/g和 1012cfu/g 數(shù)量級(jí)以上。
郝春英等對(duì)鏈霉菌Men-myco-93-63固體發(fā)酵的培養(yǎng)基和培養(yǎng)條件進(jìn)行了研究。以產(chǎn)孢量為指標(biāo),通過單一固體基質(zhì)篩選、組合固體基質(zhì)篩選及正交試驗(yàn)得到適宜鏈霉菌Men-myco-93-63產(chǎn)孢的固體培養(yǎng)基是大米:高粱:米糠:稻殼為2:2:3:3(w /w/w /w ), 試驗(yàn)中產(chǎn)孢量最高達(dá)到 2.52x109CFU/g。在此培養(yǎng)基的基礎(chǔ)上研究了裝料量、初始水料比、接種量和培養(yǎng)溫度對(duì)其產(chǎn)孢的影響。結(jié)果表明,鏈霉菌Men-myco-93-63產(chǎn)孢的適宜條件為:裝料量為15g/500mL 三角瓶,初始水料比為1.7:1.O(v /W , 不計(jì)稻殼質(zhì)量),液體接種量為7 mL,培 養(yǎng)溫度28℃。
田曉麗等探討生防放線菌153的固態(tài)發(fā)酵條件,將發(fā)酵物的含菌量作為篩選指標(biāo),以玉米粉、甘油、蔗糖、葡萄糖糖和可溶性淀粉為碳源,以小米粉、蛋白胨、酵母浸粉、黃豆粉和尿素為氮源,通過單因素試驗(yàn)獲得適宜的碳、氮源, 再 采用L25(56)正交設(shè)計(jì)優(yōu)化固體培養(yǎng)基配方, 在此基礎(chǔ)上確定固 態(tài) 發(fā) 酵 終 點(diǎn)以及所需的接種量和種子液種齡。生防放線菌153固體培養(yǎng)基配方為:80mg/g麥麩,8mg/g玉米粉,10mg/g小米粉和2mg/g蛋白胨,初始含水量(含0.5g/L石灰的自來水)為60%。在此條件下培養(yǎng), 發(fā)酵產(chǎn)物的含菌量為6.6x108CFU/g較對(duì)照增加了94.1%。
劉歡等為生防放線菌HNA30的生產(chǎn)應(yīng)用提供依據(jù),通過單因素試驗(yàn)和正交試 驗(yàn)對(duì)其固體發(fā)酵條件進(jìn)行優(yōu)化。結(jié)果表明:固體發(fā)酵的最佳基質(zhì)為麥麩,最佳碳 源為淀粉,最佳氮源為酵母提取物;菌株HNA30固體發(fā)酵的最佳條件為淀粉 50 m g/g、酵母提取物30mg/g、初始含水量400 mg/g、接種量0.35mL/g、培養(yǎng)時(shí)間168h;該條件下,HNA3O的固體發(fā)酵產(chǎn)孢量達(dá) 1.07×1010cfu/g 。
- 在線咨詢
- 在線留言
- 索要報(bào)價(jià)
- 掃一掃
掃一掃
進(jìn)入手機(jī)網(wǎng)站服務(wù)熱線
0717-4824660 - 返回頂部

